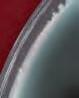

* Офетата е валидна от 04.05. до 06.05.2023 г. или до изчерпване на наличните количества -25% 749 Луканка Маджаров 190 г 999 -22% 379 Ементал слайс Goldsteig 150 г 489 -33% 299 Oриз Ризон Кrina 1 кг 449 -24% 2499 Синьо сирене 50% Viking От деликатесната витрина За 1 кг 3299 СЕГА В BILLA 1999 Aгнешко месо предна четвърт* За 1 кг СЕГА В BILLA 2099 Агнешко месо задна четвърт* За 1 кг -40% 089 Пресен чесън BILLA Градини 1 връзка 149 Градините в с. Първомай, с. Милево -27% 1899 Краве сирене БДС Маджаров От деликатесната витрина За 1 кг 2619 К А ЧЕСТВОПО BILLA -42% 199 Спанак 200 г 349 Офертата е валидна от 04.05. до 06.05.2023 г. Офертата е валидна от 04.05. до 06.05.2023 г.















































Посочените цени са в български лева с включен ДДС. -31% 499 Шоколадови бонбони After Eight 200 г 729 -33% 599 Бонбони Chocolateria Roshen 194 г 899 -21% 599 Вафли Tortina Loacker 125 г 765 -29% 3099 Уиски Black Bush 43 -25% 189 Газирана напитка Coca Cola 1,5 л 255 -16% 1669 Ракия Burgas 63 Специална 0,5 л 1999 -15% 1349 Еклерова торта с боровинки 1000 г 1599 -27% 129 Подправки Kotanyi 4 - 40 г 179 -16% 619 Бира Пиринско кен мултипак 6 х 0,5 л 745













































































































% % % % В -16% 499 Кайма смес от агнешко и телешко месо Деком 500 г 599 -23% 449 Яйца от подово отглеждани кокошки Дончево размер M 10 бр. в опакoвка 589 -25% 179 Пастет Апетит Clever 300 г 239 -26% 1089 Пушен свински врат Соколово От деликатесната витрина За 1 кг 1489 -21% 1299 Краве сирене БДС Lacrima 700 г 1659 К А ЧЕСТВОПО B LLA -40% 1599 Кашкавал от краве мляко Милея От деликатесната витрина За 1 кг 2699 -16% 249 Прясно мляко 3% BILLA 1 л 299 -25% 129 Брашно Мелница Съединение 1 кг 174 -28% 359 Домашна едросмляна лютеница или домашна Мечта Deroni 260 - 265 г 499 -34% 149 Скумрия Русалка 160 г 229



























































































% % % % BILLA Посочените цени са в български лева с включен ДДС. -30% 219 Бира Шуменско 2 л 315 -31% 115 Оризови бисквити Rice up 120 г 169 -18% 129 Кроасан 7 days 92 г 159 -39% 579 Разтворима напитка Nescafe Classic 3in1 плик 20 бр. 330 г 959 -25% 1199 Ракия Сунгурларска гроздова 0,7 л 1599 659 СЕГА В BILLA Омекотител Coccolino 58 пранета 999 СЕГА В BILLA Тоалетна хартия BILLA 3 пласта 16 бр. в опаковка 1799 СЕГА В BILLA Гел за пране Ariel 40 пранета или гел капсули Ariel Pods All in 1 28 бр. 1 опаковка 549 СЕГА В BILLA Дезодорант спрей 150 мл, рол он 50 мл или стик 40 мл Nivea 1 бр. Различни аромати -28% 049 Тунквана вафла Хипер 50 г 069


































-28% 249 Чери домати Рома 250 г 349 -41% 349 Зелени аспержи 250 г 599 -28% 249 Селъри брой 1 бр. 349 -30% 349 Червени домати 1 кг 499 Гергьовденски Сготви вкусен обяд с пресни зеленчуци -30% 349 Пиперки Сиврия 1 кг 499


































































Посочените цени са в български лева с включен ДДС. -40% 149 Авокадо 1 бр. 249 -36% 159 Ябълки червени Йонапринс 1 кг 249 -28% 249 Боровинки 125 г 349 -37% 249 Диня 1 кг 399 229 Сурови бадеми Rois 70 г В BILLA -30% 349 Малини 125 г 499 -20% 399 Грозде червено без семки 500 г 499 -40% 299 Сладки картофи 1 кг 499 -22% 349 Суров микс Супер BILLA 150 г 449





























сочна вечеря прясно месо Избери -20% 999 Прясно пиле клас А Roso За 1 кг 1249 -15% 1129 Свински флейки от бут Българска ферма За 1 кг 1329 -15% 549 Black angus бургер Grill Party 300 г 649 -15% 759 Пилешко филе с Котани марината Grill Party 650 г 899 -26% 369 Карначе Grill Party 300 г 499



























В BILLA -27% 1699 Лаврак пресен 300/400 Произход – Гърция За 1 кг 2349 Посочените цени са в български лева с включен ДДС. -27% 649 Пъстърва чистена замразена BILLA 500 г 899 599 Кордон бльо замразен Сами М 400 г НАШИТЕ МАРКИ -20% 799 Телешко шкембе Деметра 700 г 999 -31% 749 Филе от сьомга студено-пушена Primofish 100 г 1099 -18% 449 Пилешки шницел XXL Амадори 300 г 549 -16% 499 Филе от херинга, леко осолено или в олио Zigmas 240 г 599 -16% 789 Пуешки долен бут Делиа За 1 кг 949 -16% 749 Филе от треска замразено BILLA 400 г 899





























































































































-20% 229 Лаваш Dina 250 г 289 -20% 079 Рогче с маслини От BILLA пекарна 70 г 099 -30% 069 Донът шоколадов 56 г 099 -21% 259 Мелничарски хляб От BILLA пекарна 400 г 329 -27% 069 Пица закуска От BILLA пекарна 65 г 095 В BILLA За Гергьовденския обяд заложи на прясно изпечено хлебче от качествени съставки -28% 049 Мини сомун От BILLA пекарна 120 г 069 -20% 199 Софийска права баница със сирене От BILLA пекарна 170 г 249
Изобилие от вкусни



































ястия за Гергьовден


















































Посочените цени са в български лева с включен ДДС. -25% 899 Картофени дукеси От топлата витрина За 1 кг 1199 -18% 1799 Спагети Болонезе От топлата витрина За 1 кг 2199 -15% 1699 Пълнени чушки с кайма и ориз От топлата витрина За 1 кг 1999 -26% 589 Ориз със зеленчуци От топлата витрина За 1 кг 799 -20% 1999 Печена скумрия филе От топлата витрина За 1 кг 2499 -23% 999 Прясно зеле От топлата витрина За 1 кг 1299
В BILLA
-32% 249 Печен суджук От топлата витрина 1 бр. 369












































































-25% 349 Шунка BILLA 300 г 469 -23% 349 Прошуто Крудо слайс BILLA 90 г 459 -17% 289 Луканка слайс Clever 100 г 349 -29% 329 Пушено свинско филе слайс BILLA 150 г 469 НАШИТЕ МАРКИ 929 Деликатесен салам Кен 300 г цена без BILLA Card 11,79 2399 Салам Амбарица Бони От деликатесната витрина За 1 кг -50% 369 Суджук Боили Елит мес 160 г 739 -38% 399 Колбас Телешки или Хамбургски Нашенци 800 г 649 -27% 1769 Жарено свинско филе Майстор Цветко От деликатесната витрина За 1 кг 2449 * Офертата е валидна от 04.05.2023 г. до 10.05.2023 г. Само с BILLA Card. Офертата не се прилага за продукти от седмични акции (червени цени) и други стоки с намалени цени, както и за артикули с етикет „Сега в BILLA“. Отстъпката получаваш веднага на каса. Изображенията са илюстративни. -48% 399 Луканка Нашенци 250 г 769 -25% колбасиНавсичкиОРЕХИТЕсмарка * СПЕЦИАЛНАОФЕРТА


























































































1599 Розова херинга филе От деликатесната витрина За 1 кг 2529 Чешка шунка Тандем От деликатесната витрина За 1 кг -36% 599 Варена наденица с чубрица Елит мес От деликатесната витрина За 1 кг 949 -27% 579 Кренвирши Браво От деликатесната витрина За 1 кг 799 -32% 799 Едросмляна лютеница От деликатесната витрина За 1 кг 1189 -34% 1099 Разбит салатен хайвер От деликатесната витрина За 1 кг 1689 -22% 699 Салата зеле, моркови и майонеза От деликатесната витрина За 1 кг 899 599 Снежанка Оливие От деликатесната витрина За 1 кг 689 3499 Филе Елена Еко Мес От деликатесната витрина За 1 кг цена без BILLA Card 50,89 -20% Навсичкимаслини отделикатесната витрина * СПЕЦИАЛНАОФЕРТА -22% 269 Свински шницел От деликатесната витрина 1 бр. 349 Посочените цени са в български лева с включен ДДС. * Офертата е валидна от 04.05.2023 г. до 10.05.2023 г. Само с BILLA Card. Офертата не се прилага за продукти от седмични акции (червени цени) и други стоки с намалени цени, продукти с марка Clever, както и за артикули с етикет „Сега в BILLA“. Отстъпката получаваш веднага на каса. Изображенията са илюстративни.




















































В BILLA -20% продуктиНавсичкисмарка BELLAИФАМИЛИЯ* СПЕЦИАЛНАОФЕРТА ОФЕРТА -25% 299 Крем сирене за мазане Arla 200 г 399 -30% 279 Топено сирене Веселата крава 120 г 399 -20% 239 Сметана за готвене Sterilgarda 200 мл 299 -21% 329 Извара Olympus 400 г 419 -34% 329 Заквасена сметана Балкан 400 г 499 349 Руска салата с шунка Кенар 400 г цена без BILLA Card 5,29 -26% 1399 Краве сирене Болярче От деликатесната витрина За 1 кг 1899 2299 Сирене Сеждамер Mlekpol От деликатесната витрина За 1 кг 1839 Козе сирене БДС Маджаров 700 г цена без BILLA Card 23,99 К А ЧЕСТВОПО BILLA 2599 Чедър Rucker От деликатесната витрина За 1 кг цена без BILLA Card 39,99





























В BILLA -21% 469 Немско краве масло BILLA 250 г 599 -18% 179 Майонеза BILLA 200 г 219 -25% 299 Топено сирене слайс Clever 200 г 399 -18% 699 Краве сирене БДС BILLA 400 г 859 -20% айряниНавсичкиВЕРЕЯсмарка * СПЕЦИАЛНАОФЕРТА -22% 475 Прясно мляко 3% Верея 2 л 609 -30% 899 Джелато Barattolino 600 - 800 мл 1299 -21% 145 Десерт Fantasia 100 - 110 г 185 -15% 159 Kinder Maxi King 35 г 189 -17% 145 ДЗП за пиене 310 г 175 -21% 789 Грана падано, отлежало 15 месеца BILLA 200 г 999 НАШИТЕ МАРКИ Посочените цени са в български лева с включен ДДС. * Офертата е валидна от 04.05.2023 г. до 10.05.2023 г. Само с BILLA Card. Офертата не се прилага за продукти от седмични акции (червени цени) и други стоки с намалени цени, както и за артикули с етикет „Сега в BILLA“. Отстъпката получаваш веднага на каса. Изображенията са илюстративни. К А ЧЕСТВОПО BILLA












YEAR LIMITED WARRANTY А ЕК НА В И А Weber® Classic Kettle 47cm ЕНОСИ О А ЕК НА В И А Weber® Go-Anywhere Ч НЕН И АН Weber® Ø30 cm ПР В Р СТ Р В Т -50% * Всеки 10 лв. = 1 промоточка YEAR LIMITED WARRANTY *От 04.05.2023г. до 12.07.2023г. за всеки 10 лева от покупка с BILLA Card в магазини BILLA всеки клиент има право да получи 1 промоточка. Събери 10 (десет) промоточки и ги използвай с BILLA Card, за да получиш отстъпка до 50% от цената на продукт с марка Weber, включен в кампанията. Артикулите Weber и конкретният размер отстъпка от продажната цена може да видите в рекламните материали за кампания Weber. Период на кампанията от 04.05.2023г. до 12.07.2023г. вкл. или до изчерпване на количествата артикули Weber. Възможно е поради силно увеличено търсене в отделни дни някои артикули Weber временно да не са налични във всеки магазин BILLA. Виж пълните правила на кампанията във всеки магазин BILLA и на www.billa.bg. 372.00 лв цена без точки без BILLA Card 240.00 лв цена с 10 точки с BILLA Card -35% 264.00 лв цена без точки без BILLA Card 150.00лв цена с 10 точки с BILLA Card -43% 1 . 00 лв цена без точки без BILLA Card 84.00 лв цена с 10 точки с BILLA Card -50%
































































ЕС И КА А А ЕК Weber® ЧЕ КА А ОЧИС ВАНЕ НА А ЕК Weber® New КАВИ А А А ЕК Weber® ЧИ С А О ВАНЕ НА СВИНСКО ЕСО Weber® - 0.7 kg А А А О ВЕНЕ И СЕ ВИ АНЕ Weber® New 30.00 лв цена без точки без BILLA Card 18.00 лв цена с 10 точки с BILLA Card -40% И КА А О ВЕНЕ И СЕ ВИ АНЕ Weber® New 30.00 лв цена без точки без BILLA Card 18.00 лв цена с 10 точки с BILLA Card -40% 37.00 лв цена без точки без BILLA Card 22.00 лв цена с 10 точки с BILLA Card -40% ДИ И А ЕН Е О Е А АНА Weber® 59.00 лв цена без точки без BILLA Card 30.00 лв цена с 10 точки с BILLA Card -49% 43.00 лв цена без точки без BILLA Card 22.00 лв цена с 10 точки с BILLA Card -48% 55.00 лв цена без точки без BILLA Card 27.00 лв цена с 10 точки с BILLA Card -50% 22.00 лв цена без точки без BILLA Card 11.00 лв цена с 10 точки с BILLA Card -50% КО ЕК А О И ЕСНО А А ВАНЕ НА В И А Weber® (уред+брикети+кубчета) 89.00 лв цена без точки без BILLA Card 52.00 лв цена с 10 точки с BILLA Card -41% КОНСУМИРАЙ С УДОВОЛСТВИЕ И МЯРКА **Продуктът ще е наличен в магазини BILLA от 15.05.2023 г.


















































































































































Марката Ja! е собственост на REWE Zentral AG. Двуседмична валидност от 27.04. до 10.05.2023 г. -23% 329 Свинска шунка от котлет JA! 100 г 429 -22% 519 Свинска шунка суровосушена JA! 150 г 669 -18% 899 Гауда слайс JA! 400 г 1099 -21% 449 Маскарпоне JA! 250 г 569 -20% 399 Свежо сирене за мазане JA! 300 г 499 -20% 199 Млечна плодова напитка JA! 500 мл 249 -20% 349 Скир Ванилия JA! 500 г 439 -20% 599 Чили кон карне или картофи с наденица JA! 800 г 749 -21% 149 Тъмен или бял шоколад JA! 100 г 189 -20% 679 Сладолед мини класик JA! 12 х 50 мл 849 -18% 269 Кокосови сладки JA! 200 г 329





































































































































































-20% 519 Конфитюр 50% плод JA! Различни видове 450 г 649 -28% 089 Бакпулвер JA! 6 x 15 г 125 -16% 499 Мраморен кейк REWE 400 г 599 -24% 529 Фъстъчени дражета JA! 400 г 699 Посочените цени са в български лева с включен ДДС. Марката REWE Beste Wahl е собственост на REWE Zentral AG, Кьолн, Германия. -21% 899 Сладолед REWE 500 г 1149 -20% 639 Пълнозърнесто мюсли с 32% плодове JA! 1 кг 799 -28% 549 Хрупкаво мюсли REWE Различни видове 500 г 769













е в само в София *Безплатната доставка е валидна в периода 27.04.2023г. – 24.05.2023г. на територията на гр. София, като Билла България си запазва правото да променя посочения период. Запознайте се с приложимите Общи условия за използване и договаряне на glovoapp.com/en/legal/terms. Поръчайте каквото пожелаете сега с безплатна доставка*

































Посочените цени са в български лева с включен ДДС. -35% 499 Риба тон филе Ocean 185 г 769 -23% 299 Жълта леща Natura 500 г 389 -33% 299 Елда Izzi 500 г 449 199 Пасирани домати Petti 500 г цена без BILLA Card 2,99 -25% 299 Балсамов оцет от Модена BILLA 500 мл 399 -20% 119 Юфка Clever 500 г 149 НАШИТЕ МАРКИ 629 Био Лешников или Какаов крем Nocciolata 270 г -30% 449 Сос Crucials 500 мл Различни видове 649 -24% 499 Овесена напитка Not milk Alpro 1 л 659 -33% 259 Зелен грах Happy agro 690 г 389 Слънчогледово олио Реоли 1 л лв. 299 -43% -30% 279399 В BILLA

































-44% 999 Разтворимо кафе Tchibo Black&White 200 г 1799 -35% 089 Снакс Lotto Meganuts 60 г 139 -26% 949 Мляно кафе Lavazza Qualita Oro метална кутия 250 г цена без BILLA App 12,99 599 Зърнени закуски Nesquik 375 г цена без BILLA Card 8,49 -21% 149 Печени слънчогледови семки BILLA 200 г 189 -26% 179 Слепени бисквити Clever 176 г 243 -16% 499 Печени ядки микс Clever 250 г 599 В BILLA Чипс Chio 140 г лв. 299 -43% -41% 249429 -16% 199 Ментови или плодови бонбони BILLA 200 г 239 НАШИТЕ МАРКИ -23% 219 Соленки с кашкавал АЕА 200 г 285 -25% 119 Чай Букет Алеко 30 г 159











































-35% 109 Десерт Knoppers 40 г 169 -20% 419 Млечен шоколад с цели бадеми ION 200 г 529 -23% 099 Kubeti 60 г 129 -18% 269 Карамелени или медени вафли Нелис 192 г 329 -20% 379 Орехови баклавички Любимка 300 г 479 099 Руло Doma 115 г цена без BILLA Card 1,29 169 Шоколадово яйце Kinder Surprise 20 г 449 Шоколадови бонбони Черноморец 172 г -33% 159 Бисквити Роден край 165 г 239 Бисквити Milka Choco Stix или Mini Stars 112 - 150 г лв. 299 -43% -31% 219319 В BILLA 050 Кексче Barni 30 г цена без BILLA Card 0,69 Посочените цени са в български лева с включен ДДС.






































-29% 259 Студен чай San Benedetto 1,5 л 369 -17% 899 Мента Пещера 0,7 л 1085 -32% 169 Бира Heineken бутилка 0,33 л 249 -27% 239 Кафе напитка Rauch 0,250 л 329 -20% 199 Негазирана напитка Cappy Pulpy 1 л цена без BILLA App 2,49 -22% 3099 Ирландско Уиски Pogues Single Malt 0,7 л цена без BILLA App 39,99 1499 Вино Enira 0,75 л 2499 Ликьор Baileys‘ шоколад 0,5 л -22% 139 Минерална или Изворна вода Devin 2,5 л 179 Ракия Троянска сливова отлежала 0,7 л лв. 299 -43% -25% 14991999 В BILLA СЕГА В BILLA 899 Бира Efes кен 6 x 0,5 л






































Посочените цени са в български лева с включен ДДС. -27% 1599 Узо 12 0,7 л 2199 -20% 949 Вино Angel 0,75 л 1199 -24% 1899 Пенливо вино Martini Asti 0,75 л 2499 -20% 1399 Вино Menada 3 л 1769 -27% 159 Бира Ариана 1,2 л 219 1899 Джин Beefeater 0,7 л -21% 259 Сок 100% портокал BILLA 1 л 329 НАШИТЕ МАРКИ -30% 069 Газирана вода BILLA 1,5 л 099 -33% 039 Трапезна вода Clever 1,5 л 059 139 Бира Moretti кен 0,5 л цена без BILLA Card 2,15 Уиски Johnnie Walker Red Label 0,7 л лв. 299 -43% -31% 19992899 В BILLA
Бяла гъба за почистване 3 бр. Четка за миене на бутилки

за почистване на съдове 5 бр.

Микрофазерна ръкавица за почистване 1 бр.






Почистваща спирала за тръби 1 м


Стъклочистачка 24,5 х 22 см

















































Кърпа за съдове 3 бр.
Микрофазерна кърпа












































Гъби за чистене 2 бр.
Четка за почистване на съдове 29 см


Четка за чистене Duo 14 см











Посочените цени са в български лева с включен ДДС.
за сушене 1 бр. Четка за мъхове 1 бр.























































СЕГА В BILLA 1699 Кухненска ролка Emeka 3 пласта 8 + 4 бр. в опаковка -24% 529 Кухненска ролка Zebra Professional 2 пласта 1 бр. 699 -50% 1999 Филтри за вода Aquaphor Maxfor+ 3 бр. 3999 -23% 159 Лакомство за котки Zoo Royal 70 г цена без BILLA App 2,09 -26% 199 Терлици Good 39-42 и 43-46 1 чифт цена без BILLA App 2,69 249 Суха храна за котки Friskies 300 г Различни видове цена без BILLA Card 3,49 -23% 199 Пастет за кучета Zoo Royal 300 г Различни видове 259 -30% 279 Кърпи за лице BILLA 4 пласта 100 бр. в кутия 399 НАШИТЕ МАРКИ -30% 269 Тоалетно блокче Clever 2 х 48 г 389 Гел за пране Savex 20 пранета или капсули за пране Savex 2in1 15 бр. 1 опаковка Различни видове лв. 299 -43% -29% 689979 Посочените цени са в български лева с включен ДДС. В BILLA -21% 299 Алкални батерии Clever AA/AAA 8 бр. в опаковка 379











































СЕГА В BILLA 1299 Пистолет за сапунени балони 1 бр. СЕГА В BILLA 1299 Детска топка за скачане с дръжка 55 см 1 бр. СЕГА В BILLA 3499 Скейтборд до 80 кг 1 бр. Посочените цени са в български лева с включен ДДС. СЕГА В BILLA 6499 Баланс колело 80 см Рамка до 40 кг 1 бр. СЕГА В BILLA 1599 Машина за мехурчета 1 бр. СЕГА В BILLA 1499 Хвърчило различен дизайн 115 x 63 1 бр. СЕГА В BILLA 1999 Люлка с включено въже 1 бр. СЕГА В BILLA 4999 Сгъваема тротинетка за деца до 50 кг 1 бр.

































































СЕГА В BILLA 449 Шампоан 400 мл или Балсам 250 мл Schauma 1 бр. -29% 259 Течен сапун Medix Cream Collection 800 мл пълнител 365 -50% 399 Душ гел Fa 400 мл 805 1399 Гел за съдомиялна Finish Classic 1,5 л 499 Паста за зъби Sensodyne Fluoride 75 мл 199 Мокри кърпи Бочко 64 бр. в опаковка Посочените цени са в български лева с включен ДДС. * Офертата е валидна от 04.05.2023 г. до 10.05.2023 г. Само с BILLA Card. Офертата не се прилага за продукти от седмични акции (червени цени) и други стоки с намалени цени, както и за артикули с етикет „Сега в BILLA“. Отстъпката получаваш веднага на каса. Изображенията са илюстративни. -31% 129 Салфетки Santia Българска шевица 33/25 100 бр. в опаковка цена без BILLA App 1,89 СЕГА В BILLA 1049 Боя за коса Loreal Excellence 1 опаковка Различни цветове СЕГА В BILLA 389 Паста за зъби Aquafresh Intense Clean Whitening 75 мл -25% продуктиНавсичкиLIBRESSEсмарка * СПЕЦИАЛНАОФЕРТА СЕГА В BILLA 239 Антибактериални мокри кърпи Wet Hankies 2 + 2 бр.






































Посочените цени са в български лева с включен ДДС. СЕГА В BILLA 699 Бегония саксия Ф 12 1 бр. СЕГА В BILLA 399 Хризантема саксия Ф 12 1 бр. СЕГА В BILLA 699 Кала саксия Ф 10,5 1 бр. СЕГА В BILLA 399 Сентполия саксия Ф 12 1 бр. СЕГА В BILLA 1199 Орхидея Фаленопсис саксия Ф 12 1 бр. СЕГА В BILLA 599 Бромелия саксия Ф 9 1 бр. СЕГА В BILLA 449 Лалета 7 бр. букет 1 бр.














































































































Офертата е валидна от 01.05.2023 г. до 31.05.2023 г. Посочените цени са в български лева с включен ДДС. 1299 СЕГА В BILLA Моята първа книга с игри 1 брой МАЙ
дошъл В еКИПА!
BILLA БЪЛГАРИЯ ЩЕ СЕ ПОГРИЖИ ЗА УСПЕШНИЯ СТАРТ НА КАРИЕРАТА ТИ
СТАБИЛЕН РАБОТОДАТЕЛ С КОРЕКТНО ОТНОШЕНИЕ
ГЪВКАВО РАБОТНО ВРЕМЕ НА СМЕНИ В СУПЕРМАРКЕТ НА ВОДЕЩА ТЪРГОВСКА ВЕРИГА
ЕНЕРГИЧЕН ЕКИП И ПОЗИТИВНА РАБОТНА СРЕДА
ВЪВЕЖДАЩО ОБУЧЕНИЕ И ВЪЗМОЖНОСТИ ЗА КАРИЕРНО РАЗВИТИЕ

Свържисеснасипопитай засвободнипозициина jobs@billa.bg
















































или на място във всеки магазин
ДОПЪЛНИТЕЛНИ
ПРИДОБИВКИ ЩЕ ОБЕЗПЕЧАТ
ВАЖНИТЕ ЗА ТЕБ НЕЩА:
200 лева ваучери за храна месечно
Допълнително здравно осигуряване

Профилактични прегледи и подновяване на лични здравни книжки








Бонус програми и отстъпки
Социален фонд в подкрепа на служители при здравословни проблеми
„Стартов пакет“ и финансов бонус при раждане на дете 500 лв. бруто

-НЕДЕЛЯ













НА ВСИЧКИ КАШКАВАЛИ*

НА ВСИЧКИ ВИДОВЕ ВОДКА*






НА ВСИЧКИ ПОЧИСТВАЩИ
ПРЕПАРАТИ И ПОСОБИЯ


























ЗА ПОЧИСТВАНЕ*





С този знак се обозначават продукти, които могат да бъдат закупени еднократно на обявената цена с отстъпка при едновременно маркиране на каса на дигитален ваучер и BILLA Card. Ваучерите са достъпни в приложението BILLA App и на www.billa.bg. Ограниченията в закупуваните количества и срокът на валидност на офертата са посочени на ваучера. Продуктите могат да бъдат закупени без дигитален ваучер на продажната цена, обявена на етикета в магазина. Отстъпката получаваш веднага на каса. Повече в BILLA App и на www.billa.bg.











С този знак се означават продукти, които не са налични в магазини BILLA: София, бул. Цариградско шосе 12, бул. Цар Освободител





ул. Раковски 116, пл. Лъвов мост 2, ул. Пиротска 9, бул. Кн. Ал. Дондуков Корсаков
Дубровник 46, бул. Кн. Борис I 99; Русе, ул. Н. Бозвели 18, пл. Свобода 7; Ст. Загора, ул. Кн. Борис 93, бул. Цар Симеон Велики 105 А; Хасково, пл. Общински 3; Плевен, пл. Свобода 25; Кюстендил, ул. Пауталия 10; В. Търново, ул. Г. Измирлиев 13А; Монтана, ул. Акад. И. Дуриданов 2; Кърджали, кв. Възрожденци, ул. „Баба Тонка“ 24.

























лева с включен ДДС. BILLA не носи отговорност за допуснати печатни грешки. BILLA си запазва правото да променя цените. Повече на www.billa.bg

ВЕЧЕ И С НАШИТЕ МАРКИ
-25% ГРАНДЕ ОФЕРТА3XПЕТЪК05.05.-07.05.
* Офертата е валидна от 05.05.2023 г. до 07.05.2023 г. или до изчерпване на наличните количества. Само с BILLA Card. Офертата не се прилага за продукти от седмични акции (червени цени), артикули с етикет „Сега в BILLA“, както и за други стоки с намалени цени. Отстъпката получаваш веднага на каса. Изображенията са илюстративни. НАЦИОНАЛЕН ТЕЛЕФОН НА КЛИЕНТА 0700 120 10 СВЪРЖИ СЕ С НАС НА ЦЕНАТА НА ЕДИН ГРАДСКИ РАЗГОВОР Събирайте използваната хартия за рециклиране. Всички оферти са валидни до изчерпване на количествата, като стоките се продават в количества, предназначени за домакинството. Посочените цени са в български
22,
11, ул. В. Белински 2Б, ул. Славянска 5, ул. П. Зографски 38, ул. Р. Алексиев 40, бул. Ал. Стамболийски 247-В; Пловдив, ул. Р. Даскалов 8, ул. Черешово топче 2; Бургас, ул. Александровска 58, ж.к. Изгрев, бл. 178, ул. Слънце 30; Варна, ул. Д. Икономов 36, ул.
СТАРТ















































































































































ПН 08.05. 09.05. ВТ 10.05. СР
Супер
-50 % ДО Посочените цени са в български лева с включен ДДС. Кайма Народен Различни видове охладена 250 г -31% 199289 Уиски Claymore 0,7 л -50% 11992399 Инстантни спагети Banetti 75 г -36% 069109 Русенско варено The Chefs 300 г -50% 189379 Луканка Ханове 600 г -33% 9991499 Тоалетна хартия Emeka Paradise 3 пласта 8 бр. в опаковка -36% 569899 Лимони 1 кг -40% 179299 Ранно зеле BILLA Градини 1 кг -25% 149199 Градините в с. Първомай Кисело мляко 2% Саяна 400 г -36% 099155 Мляно кафе Nova Brasilia 100 г -28% 189265 Бира Каменица кен 0,5 л -35% 109169